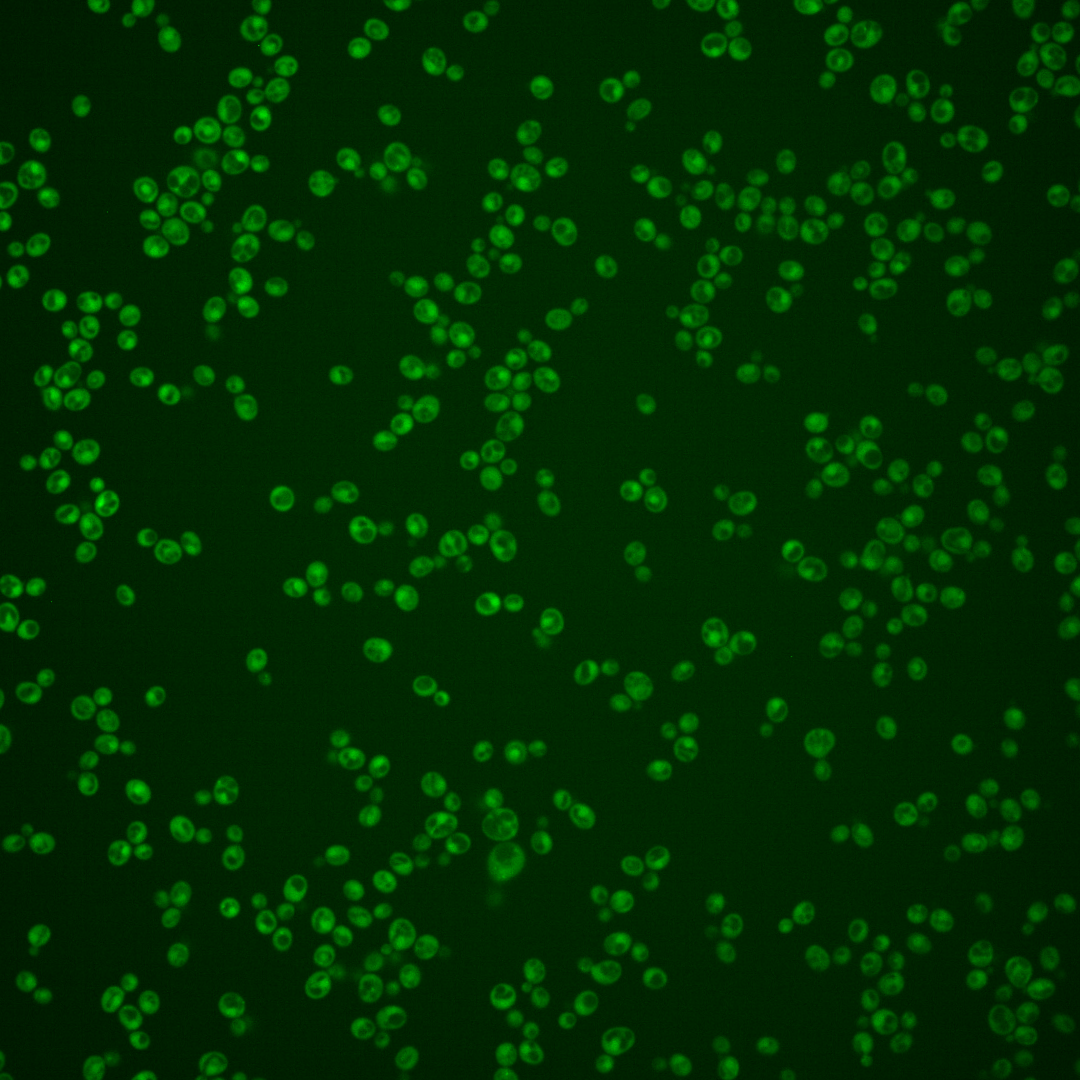
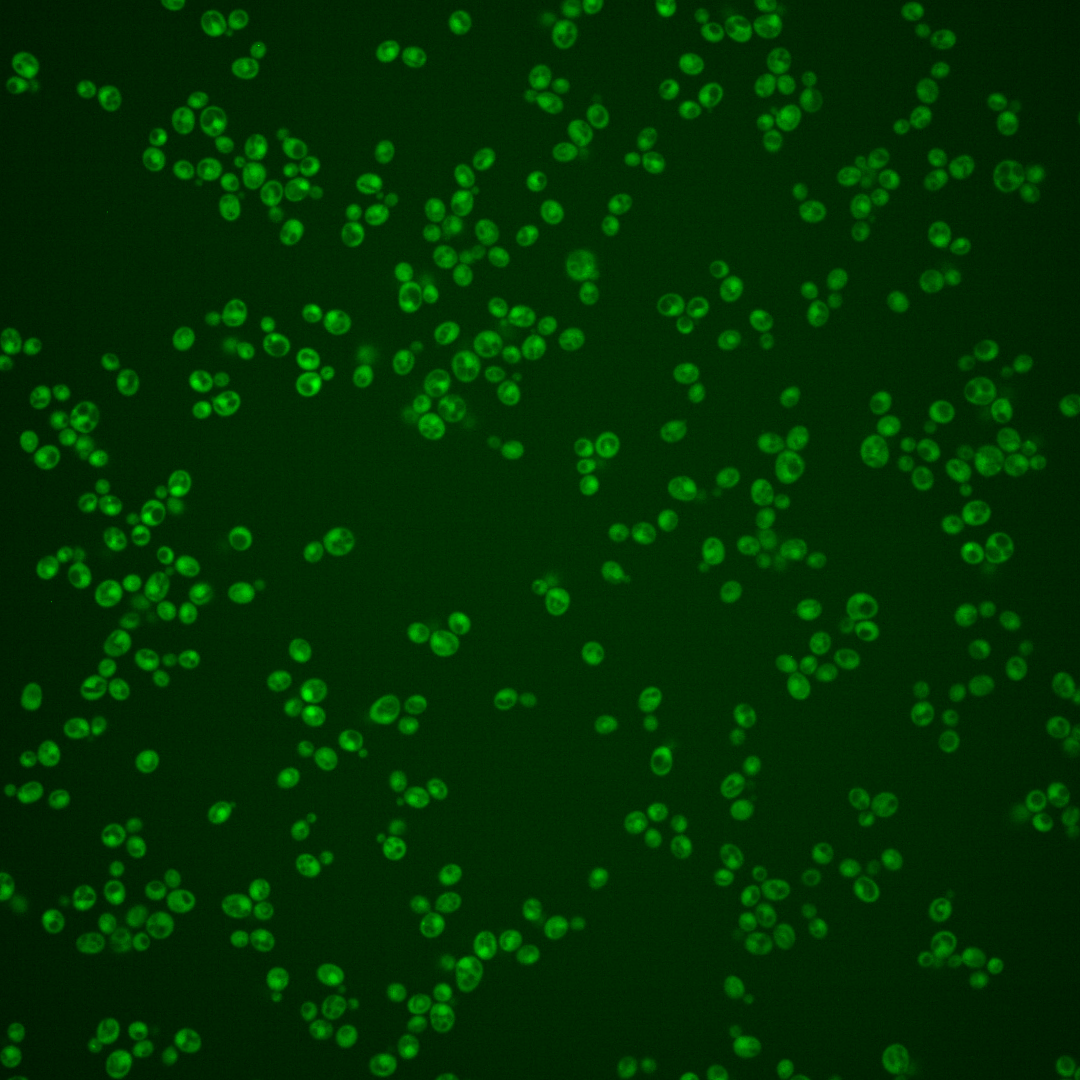
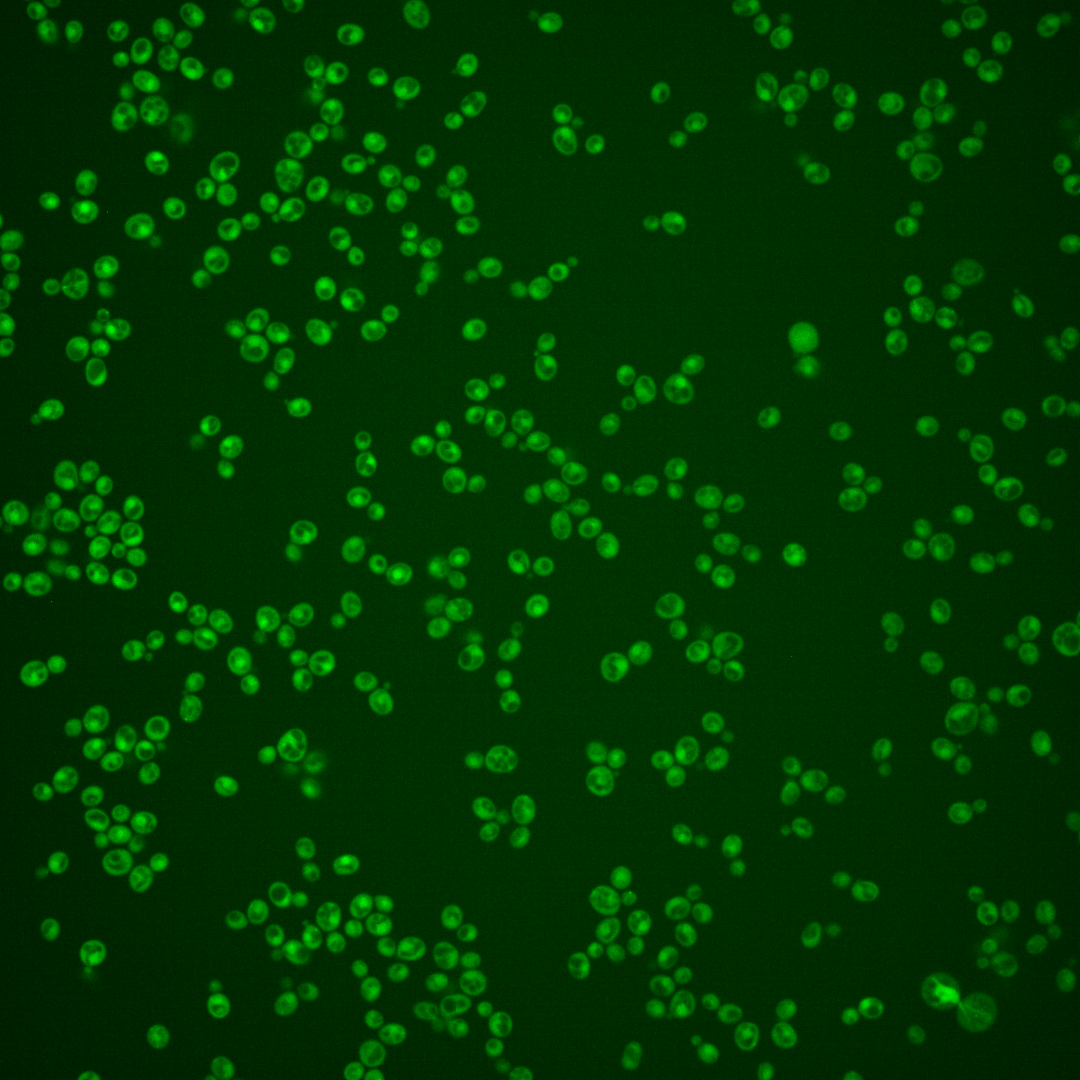

| Standard name | |
|---|---|
| Human Ortholog | |
| Description | Protein of unknown function; contains a J-domain, which is a region with homology to the E. coli DnaJ protein |
Micrographs




















































































Sub-cellular Localization
Yeast GFP Assignment
Protein Abundance
Localization Change
External localization resources
| ensLOC | DeepLoc | |||||||||||||||||||||||
|---|---|---|---|---|---|---|---|---|---|---|---|---|---|---|---|---|---|---|---|---|---|---|---|---|
| Localization | WT1 | WT2 | WT3 | RAP60 | RAP140 | RAP220 | RAP300 | RAP380 | RAP460 | RAP540 | RAP620 | RAP700 | HU80 | HU120 | HU160 | rpd3Δ_1 | rpd3Δ_2 | rpd3Δ_3 | WT1 | WT2 | WT3 | AF100 | AF140 | AF180 |
| Cortical Patches | 0 | 0 | 0 | 0 | 0 | 0 | 0 | 0 | 0 | 0 | 0 | 0 | 0 | 0 | 0 | – | 0 | 1 | 6 | 0 | 3 | 1 | 1 | 5 |
| Bud | 0 | 0 | 3 | 0 | 1 | 7 | 6 | 9 | 13 | 13 | 5 | 7 | 3 | 0 | 1 | – | 0 | 1 | 1 | 0 | 1 | 0 | 3 | 8 |
| Bud Neck | 0 | 0 | 0 | 0 | 1 | 2 | 0 | 3 | 0 | 1 | 1 | 0 | 0 | 0 | 0 | – | 0 | 2 | 1 | 0 | 1 | 0 | 0 | 2 |
| Bud Site | 0 | 0 | 0 | 0 | 0 | 0 | 1 | 3 | 5 | 3 | 5 | 5 | 0 | 0 | 0 | – | 0 | 0 | – | – | – | – | – | – |
| Cell Periphery | 0 | 0 | 0 | 0 | 0 | 0 | 1 | 0 | 0 | 1 | 1 | 0 | 0 | 0 | 2 | – | 0 | 0 | 0 | 0 | 0 | 0 | 0 | 0 |
| Cytoplasm | 261 | 12 | 173 | 151 | 221 | 249 | 306 | 293 | 164 | 214 | 157 | 185 | 183 | 501 | 426 | – | 213 | 190 | 250 | 54 | 125 | 127 | 279 | 309 |
| Endoplasmic Reticulum | 2 | 1 | 1 | 0 | 1 | 0 | 0 | 0 | 1 | 0 | 0 | 0 | 0 | 1 | 4 | – | 16 | 17 | 1 | 0 | 3 | 1 | 1 | 2 |
| Endosome | 0 | 0 | 1 | 0 | 5 | 3 | 3 | 3 | 5 | 1 | 0 | 0 | 2 | 10 | 11 | – | 11 | 15 | 11 | 0 | 4 | 2 | 1 | 7 |
| Golgi | 0 | 0 | 0 | 0 | 0 | 0 | 0 | 0 | 0 | 0 | 0 | 0 | 0 | 1 | 0 | – | 1 | 0 | 0 | 0 | 1 | 0 | 1 | 2 |
| Mitochondria | 102 | 9 | 35 | 44 | 63 | 224 | 320 | 315 | 287 | 354 | 294 | 392 | 5 | 2 | 1 | – | 13 | 6 | 44 | 2 | 30 | 9 | 22 | 23 |
| Nucleus | 0 | 0 | 1 | 0 | 0 | 5 | 8 | 15 | 16 | 13 | 13 | 11 | 0 | 0 | 0 | – | 3 | 2 | 6 | 1 | 1 | 4 | 4 | 1 |
| Nuclear Periphery | 1 | 2 | 0 | 0 | 0 | 0 | 3 | 1 | 0 | 3 | 2 | 3 | 0 | 0 | 0 | – | 1 | 0 | 1 | 0 | 0 | 0 | 0 | 0 |
| Nucleolus | 0 | 0 | 0 | 0 | 0 | 1 | 2 | 2 | 2 | 0 | 1 | 1 | 0 | 0 | 1 | – | 0 | 0 | 0 | 0 | 0 | 0 | 0 | 0 |
| Peroxisomes | 0 | 0 | 0 | 0 | 0 | 0 | 1 | 0 | 1 | 1 | 0 | 0 | 0 | 0 | 2 | – | 0 | 0 | 0 | 0 | 0 | 0 | 0 | 0 |
| SpindlePole | 1 | 0 | 2 | 0 | 0 | 4 | 10 | 14 | 7 | 11 | 5 | 2 | 0 | 4 | 7 | – | 6 | 7 | 9 | 0 | 5 | 3 | 4 | 9 |
| Vac/Vac Membrane | 12 | 1 | 16 | 27 | 34 | 22 | 42 | 11 | 17 | 21 | 11 | 17 | 18 | 23 | 8 | – | 26 | 16 | 30 | 7 | 15 | 13 | 10 | 20 |
| Unique Cell Count | 330 | 20 | 198 | 195 | 289 | 419 | 571 | 567 | 398 | 496 | 393 | 487 | 200 | 529 | 451 | 249 | 232 | 378 | 71 | 199 | 169 | 337 | 400 | |
| Labelled Cell Count | 379 | 25 | 232 | 222 | 326 | 517 | 703 | 669 | 518 | 636 | 495 | 623 | 211 | 542 | 463 | 290 | 257 | 378 | 71 | 199 | 169 | 337 | 400 | |
Yeast GFP Assignment
Protein Abundance
| Screen | WT1 | WT2 | WT3 | RAP60 | RAP140 | RAP220 | RAP300 | RAP380 | RAP460 | RAP540 | RAP620 | RAP700 | HU80 | HU120 | HU160 | rpd3Δ_1 | rpd3Δ_2 | rpd3Δ_3 | AF100 | AF140 | AF180 |
|---|---|---|---|---|---|---|---|---|---|---|---|---|---|---|---|---|---|---|---|---|---|
| Mean Cell GFP Intensity (1e-4) | 3.3 | 3.3 | 3.7 | 3.7 | 3.6 | 3.2 | 2.8 | 3.2 | 3.1 | 2.8 | 3.0 | 2.6 | 4.1 | 4.1 | 4.3 | 4.5 | 4.9 | 5.5 | 3.9 | 4.0 | 4.6 |
| Std Deviation (1e-4) | 0.4 | 0.4 | 1.3 | 1.4 | 1.2 | 1.1 | 0.8 | 1.2 | 1.5 | 1.4 | 1.3 | 1.0 | 0.9 | 1.1 | 1.5 | 1.4 | 1.4 | 1.4 | 0.9 | 1.5 | 1.6 |
| Intensity Change (Log2) | – | – | – | 0.01 | -0.02 | -0.2 | -0.37 | -0.2 | -0.24 | -0.39 | -0.31 | -0.5 | 0.15 | 0.15 | 0.23 | 0.28 | 0.42 | 0.59 | 0.09 | 0.13 | 0.32 |
Localization Change
| Localization | RAP60 | RAP140 | RAP220 | RAP300 | RAP380 | RAP460 | RAP540 | RAP620 | RAP700 | HU80 | HU120 | HU160 | rpd3Δ_1 | rpd3Δ_2 | rpd3Δ_3 |
|---|---|---|---|---|---|---|---|---|---|---|---|---|---|---|---|
| Actin | – | – | – | – | – | – | – | – | – | – | – | – | – | – | – |
| Bud | – | – | – | – | – | – | – | – | – | – | – | – | – | 0 | 0 |
| Bud Neck | – | – | – | – | – | – | – | – | – | – | – | – | – | 0 | 0 |
| Bud Site | – | – | – | – | – | – | – | – | – | – | – | – | – | 0 | 0 |
| Cell Periphery | – | – | – | – | – | – | – | – | – | – | – | – | – | 0 | 0 |
| Cyto | – | – | – | – | – | – | – | – | – | – | – | – | – | – | – |
| Endoplasmic Reticulum | – | – | – | – | – | – | – | – | – | – | – | – | – | 0 | 0 |
| Endosome | – | – | – | – | – | – | – | – | – | – | – | – | – | 0 | 0 |
| Golgi | – | – | – | – | – | – | – | – | – | – | – | – | – | 0 | 0 |
| Mitochondria | – | – | – | – | – | – | – | – | – | – | – | – | – | 0 | 0 |
| Nuclear Periphery | – | – | – | – | – | – | – | – | – | – | – | – | – | 0 | 0 |
| Nuc | – | – | – | – | – | – | – | – | – | – | – | – | – | – | – |
| Nucleolus | – | – | – | – | – | – | – | – | – | – | – | – | – | 0 | 0 |
| Peroxisomes | – | – | – | – | – | – | – | – | – | – | – | – | – | 0 | 0 |
| SpindlePole | – | – | – | – | – | – | – | – | – | – | – | – | – | 0 | 0 |
| Vac | – | – | – | – | – | – | – | – | – | – | – | – | – | – | – |
| Cortical Patches | – | – | – | – | – | – | – | – | – | – | – | – | – | 0 | 0 |
| Cytoplasm | – | – | – | – | – | – | – | – | – | – | – | – | – | 0 | 0 |
| Nucleus | – | – | – | – | – | – | – | – | – | – | – | – | – | 0 | 0 |
| Vacuole | – | – | – | – | – | – | – | – | – | – | – | – | – | 0.8 | -0.5 |
External localization resources
Images






























Protein Concentration and Protein Localization Data
| R1 | R2 | R3 | ||||||||||||||||
|---|---|---|---|---|---|---|---|---|---|---|---|---|---|---|---|---|---|---|
| G1 Pre-START | G1 Post-START | S/G2 | Metaphase | Anaphase | Telophase | G1 Pre-START | G1 Post-START | S/G2 | Metaphase | Anaphase | Telophase | G1 Pre-START | G1 Post-START | S/G2 | Metaphase | Anaphase | Telophase | |
| Concentration | -1.3891 | -0.882 | -1.1235 | -1.1142 | -0.9566 | -0.923 | 0.2122 | -0.1701 | -0.433 | -0.5462 | -0.3911 | -0.4801 | 0.8208 | 0.653 | 0.4116 | 0.1922 | 0.3194 | 0.2861 |
| Actin | 0.0296 | 0.0002 | 0.0202 | 0.0263 | 0.0457 | 0.0021 | 0.0515 | 0.007 | 0.0139 | 0 | 0.0177 | 0.0034 | 0.0841 | 0.0002 | 0.0014 | 0.0017 | 0.0624 | 0.0081 |
| Bud | 0.0003 | 0.0001 | 0.0003 | 0.0001 | 0.0005 | 0.0001 | 0.0019 | 0.0003 | 0.0003 | 0 | 0.0008 | 0.0001 | 0.0012 | 0.0002 | 0 | 0.001 | 0.0001 | 0.0005 |
| Bud Neck | 0.0015 | 0.0002 | 0.0006 | 0.0003 | 0.0011 | 0.0014 | 0.0031 | 0.0003 | 0.0007 | 0 | 0.0002 | 0.0007 | 0.0067 | 0.0001 | 0.0001 | 0.0002 | 0.001 | 0.0013 |
| Bud Periphery | 0.0005 | 0.0001 | 0.0004 | 0.0001 | 0.0012 | 0.0001 | 0.0022 | 0.001 | 0.0005 | 0 | 0.0014 | 0.0001 | 0.002 | 0.0003 | 0 | 0.002 | 0.0001 | 0.0016 |
| Bud Site | 0.0026 | 0.007 | 0.0007 | 0.0006 | 0.0007 | 0.0001 | 0.0123 | 0.0038 | 0.0096 | 0 | 0.0003 | 0.0001 | 0.0049 | 0.0011 | 0.0003 | 0.0004 | 0.0002 | 0.0001 |
| Cell Periphery | 0.0003 | 0.0001 | 0.0001 | 0 | 0.0002 | 0 | 0.0003 | 0.0002 | 0.0006 | 0 | 0 | 0 | 0.0005 | 0.0001 | 0 | 0.0002 | 0 | 0 |
| Cytoplasm | 0.0962 | 0.1583 | 0.1277 | 0.2011 | 0.1461 | 0.2011 | 0.0364 | 0.1081 | 0.0699 | 0.0084 | 0.0474 | 0.1284 | 0.0683 | 0.144 | 0.1516 | 0.1395 | 0.1523 | 0.1534 |
| Cytoplasmic Foci | 0.0277 | 0.0155 | 0.0226 | 0.0138 | 0.0265 | 0.0486 | 0.0425 | 0.0214 | 0.0162 | 0.0004 | 0.0054 | 0.0207 | 0.0401 | 0.0267 | 0.0146 | 0.0142 | 0.0175 | 0.0244 |
| Eisosomes | 0.0008 | 0.0001 | 0.0003 | 0.0001 | 0.0009 | 0.0002 | 0.0009 | 0.0006 | 0.0007 | 0.0001 | 0.0002 | 0.0001 | 0.0027 | 0.0001 | 0.0001 | 0.0002 | 0.0003 | 0.0001 |
| Endoplasmic Reticulum | 0.0034 | 0.0053 | 0.0022 | 0.0037 | 0.0055 | 0.0023 | 0.0032 | 0.0035 | 0.0024 | 0.0001 | 0.0004 | 0.0021 | 0.0046 | 0.002 | 0.0025 | 0.0025 | 0.0012 | 0.0016 |
| Endosome | 0.0113 | 0.0128 | 0.0028 | 0.0103 | 0.0179 | 0.0062 | 0.0189 | 0.002 | 0.0101 | 0 | 0.004 | 0.006 | 0.0218 | 0.0019 | 0.007 | 0.0081 | 0.0043 | 0.0049 |
| Golgi | 0.0033 | 0.0006 | 0.0015 | 0.0051 | 0.0099 | 0.0005 | 0.011 | 0.0005 | 0.0054 | 0 | 0.0109 | 0.0059 | 0.0084 | 0.0002 | 0.0004 | 0.0005 | 0.0032 | 0.0011 |
| Lipid Particles | 0.0084 | 0.0039 | 0.0012 | 0.0044 | 0.0252 | 0.0028 | 0.0272 | 0.0024 | 0.0043 | 0 | 0.0011 | 0.0024 | 0.024 | 0.0007 | 0.0009 | 0.0009 | 0.0039 | 0.0066 |
| Mitochondria | 0.0029 | 0.0003 | 0.0087 | 0.0011 | 0.0053 | 0.0006 | 0.0107 | 0.0006 | 0.0105 | 0 | 0.0289 | 0.0027 | 0.0082 | 0.0007 | 0.0003 | 0.0028 | 0.0005 | 0.0029 |
| None | 0.7853 | 0.7748 | 0.7778 | 0.7137 | 0.6753 | 0.6738 | 0.6863 | 0.8357 | 0.8309 | 0.9907 | 0.8724 | 0.7997 | 0.6341 | 0.792 | 0.7889 | 0.8087 | 0.7141 | 0.7632 |
| Nuclear Periphery | 0.0056 | 0.005 | 0.0029 | 0.0033 | 0.0167 | 0.0029 | 0.0146 | 0.0011 | 0.0028 | 0.0001 | 0.0009 | 0.002 | 0.007 | 0.0013 | 0.0024 | 0.0019 | 0.0024 | 0.0026 |
| Nucleolus | 0.0016 | 0.0007 | 0.0006 | 0.0005 | 0.0008 | 0.0009 | 0.0013 | 0.0005 | 0.0004 | 0 | 0.0003 | 0.0002 | 0.0011 | 0.0008 | 0.0003 | 0.0005 | 0.0004 | 0.0005 |
| Nucleus | 0.0067 | 0.0047 | 0.0094 | 0.0072 | 0.0054 | 0.0303 | 0.0055 | 0.0035 | 0.0013 | 0 | 0.001 | 0.0163 | 0.003 | 0.0088 | 0.0183 | 0.0038 | 0.0179 | 0.0057 |
| Peroxisomes | 0.0042 | 0.0002 | 0.0056 | 0.002 | 0.0043 | 0.0093 | 0.0296 | 0.0037 | 0.002 | 0 | 0.0047 | 0.003 | 0.0612 | 0.0027 | 0.0009 | 0.0038 | 0.0054 | 0.0083 |
| Punctate Nuclear | 0.0054 | 0.0084 | 0.0138 | 0.0045 | 0.0074 | 0.0157 | 0.0371 | 0.0026 | 0.016 | 0.0001 | 0.0014 | 0.0053 | 0.0139 | 0.0149 | 0.0092 | 0.0021 | 0.012 | 0.0123 |
| Vacuole | 0.0018 | 0.0014 | 0.0006 | 0.0014 | 0.0016 | 0.0008 | 0.0024 | 0.0013 | 0.0011 | 0 | 0.0004 | 0.0006 | 0.0013 | 0.0009 | 0.0007 | 0.0046 | 0.0005 | 0.0007 |
| Vacuole Periphery | 0.0007 | 0.0002 | 0.0002 | 0.0003 | 0.0017 | 0.0002 | 0.0012 | 0.0001 | 0.0003 | 0 | 0.0003 | 0.0001 | 0.0008 | 0.0001 | 0.0001 | 0.0006 | 0.0001 | 0.0002 |
Sequencing Data
| R1 | R2 | |||||||||
|---|---|---|---|---|---|---|---|---|---|---|
| G1 Post-START | S/G2 | Metaphase | Anaphase | Telophase | G1 Post-START | S/G2 | Metaphase | Anaphase | Telophase | |
| Gene Expression | 5.3533 | 5.63 | 5.8488 | 7.0727 | 7.7573 | 6.9239 | 7.8272 | 9.6051 | 7.7212 | 8.1029 |
| Translational Efficiency | 1.243 | 1.0306 | 1.0615 | 0.8339 | 0.7655 | 0.852 | 0.7359 | 0.5706 | 0.7641 | 0.9235 |
Hit Data
| Dataset | Hit |
|---|---|
| Protein Concentration | ✘ |
| Protein Localization | ✘ |
| Gene Expression | ✘ |
| Translational Efficiency | ✘ |
Endocytosis
| Temp | Actin Patch (Sac6-tdTomato) | Cortical Patch (Sla1-GFP) | Late Endosome (Snf7-GFP) | Vacuole (Vph1-GFP) |
|---|---|---|---|---|
| 37℃ | ||||
| RT |
Cell Cycle Omics
CYCLoPs (Jjj2-GFP)
| Gene / Allele | Actin Patch (Sac6-tdTomato) | Cortical Patch (Sla1-GFP) | Late Endosome (Snf7-GFP) | Vacuole (Sac6-tdTomato) |
|---|
| Gene | Images |
|---|
| Gene | Images |
|---|
Images are not yet available
Images are not yet available